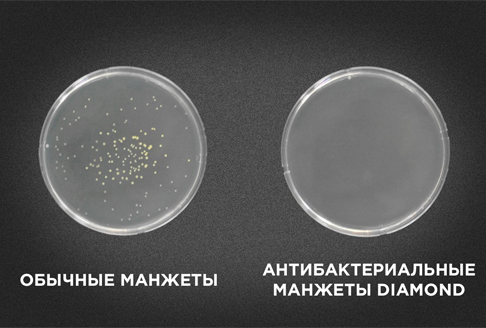

WelbuTech Seven Liner Zam Luxury Z-Sport — это профессиональный физиотерапевтический аппарат нового поколения, созданный специально для спортсменов и людей, ведущих активный образ жизни. Благодаря своему функционалу и высокой эффективности он идеально подходит для быстрого восстановления после тренировок, снятия мышечного напряжения и улучшения кровообращения.
Аппарат имеет регистрационное удостоверение Росздравнадзора и может использоваться в медицинских учреждениях, спортивных клубах, салонах красоты и дома. В комплекте представлены манжеты для ног (размер XXL), руки и талии — всё, что нужно для комплексной работы с телом.
Область применения
- ✔️ Профессиональный и домашний спортивный массаж
- ✔️ Восстановление после физических нагрузок
- ✔️ Профилактика и устранение отёков
- ✔️ Улучшение лимфо- и кровообращения
- ✔️ Снятие мышечной боли и спазмов
- ✔️ Улучшение тонуса кожи и тканей
- ✔️ Комплексная реабилитация после травм

Особенности и преимущества
- ➕ Пятикамерные манжеты с индивидуальной анатомической выкройкой стопы обеспечивают точное распределение давления и комфортную проработку всех зон.
- ➕ Регулируемое давление до 250 мм рт. ст. — подходит как для лёгкой стимуляции, так и для глубокой мышечной проработки.
- ➕ 4 полноценных режима работы: массаж, лимфодренаж, прессотерапия и автоматический.
- ➕ Выборочное отключение камер — возможность исключать зоны травм или акцентировать воздействие на отдельные участки тела.
- ➕ Цифровой датчик давления — обеспечивает точную и безопасную настройку под индивидуальные параметры пользователя.
- ➕ Голосовой информатор и световая индикация упрощают использование.
- ➕ Сенсорная панель управления с интуитивно понятным интерфейсом.
- ➕ Манжеты из антибактериальной ткани Oxford Diamond — прочные, гигиеничные, устойчивые к износу и легко очищаются.
- ➕ Размер XXL — редкость на рынке, идеально подходит для людей с крупным телосложением.
- ➕ Совместим с несколькими манжетами одновременно (ботфорты, рукав, пояс).
Функции аппарата
Массаж
Камеры накачиваются поочерёдно: создаётся эффект глубокого и ритмичного ручного массажа, способствующего расслаблению и снятию напряжения.
Лимфодренаж
Камеры надуваются снизу вверх, предыдущие остаются надутыми — обеспечивается эффективный лимфоток и выведение продуктов метаболизма.
Прессотерапия
Одновременное наполнение всех камер создаёт равномерное давление на ткани, улучшая тонус, уменьшение отёков и восстановление капиллярного кровотока.
Автоматический режим
Последовательно активирует все вышеперечисленные программы — идеально подходит для комплексной профилактики и восстановления.
WelbuTech Seven Liner Zam Luxury Z-Sport — это выбор профессионалов, которым важна каждая деталь: от надёжной конструкции до персонализированных настроек. Оцените комфорт, эффективность и качество аппарата, разработанного с учётом потребностей современных спортсменов и активных пользователей.
| Бренд | WelbuTech |
| Страна | Южная Корея |
| Напряжение и частота сети питания | 100–240 В / 50–60 Гц |
| Длительность процедур | 15 / 20 / 30 мин |
| Длина воздуховодной трубки | 125 см (± 3 см) |
| Режимы работы | Массаж, Лимфодренаж, Прессотерапия, Авто-режим |
| Мощность | 45 Вт |
| Применение | Спортивный массаж |
| Габариты | 230 × 140 × 240 мм |
| Вес | 1,97 кг |
| Максимальное давление в камерах | 250 мм рт. ст. |
| Таймер | цифровой |
| Регулировка интенсивности стимуляции | нет |
| Обратная волна | Нет |
| Количество главных режимов | 4 |
| Количество камер | 5 |
| Регулировка давления | Плавная |
| Голосовое сопровождение | Да |
| Размер манжет для ног | XXL |
| Доступные размеры ботфортов | L, XL, XXL |
| Фиксация шлангов в камерах манжет | Да |
| Скрытые шланги на манжетах | Да |
| Расширители манжет для ног | есть (доп. опция) |
| Манжета шорты | Да |
| Пульт ДУ | Нет |
| Кнопки | сенсорные |
| Принудительный спуск воздуха | Да |
| Выборочное отключение камер | Да |
| Индикация рабочей камеры | Да |
| Длина шнура электропитания | 1,5 м |
| Комбинирование манжет | Да (доп. опция) |
В данном комплекте Zam Luxury Z-Sport присутствуют:
- Блок управления - 1шт.;
- Шнур питания - 1шт.;
- Манжеты для ног с треугольной стопой и карманом для шлангов - 1 пара;
- Пакет полиэтиленовый для хранения манжет - 1 шт.;
- Манжета для руки; - 1 шт.;
- Манжета для талии; - 1 шт.;
- Шланг-воздуховод двухлинейный соединительный для манжет ног/шорт - 1 шт.;
- Шланг-воздуховод однолинейный соединительный для манжеты талии (пояса) - 1 шт.;
- Шланг-воздуховод однолинейный соединительный для манжеты руки - 1 шт.;
- Руководство по эксплуатации.





























